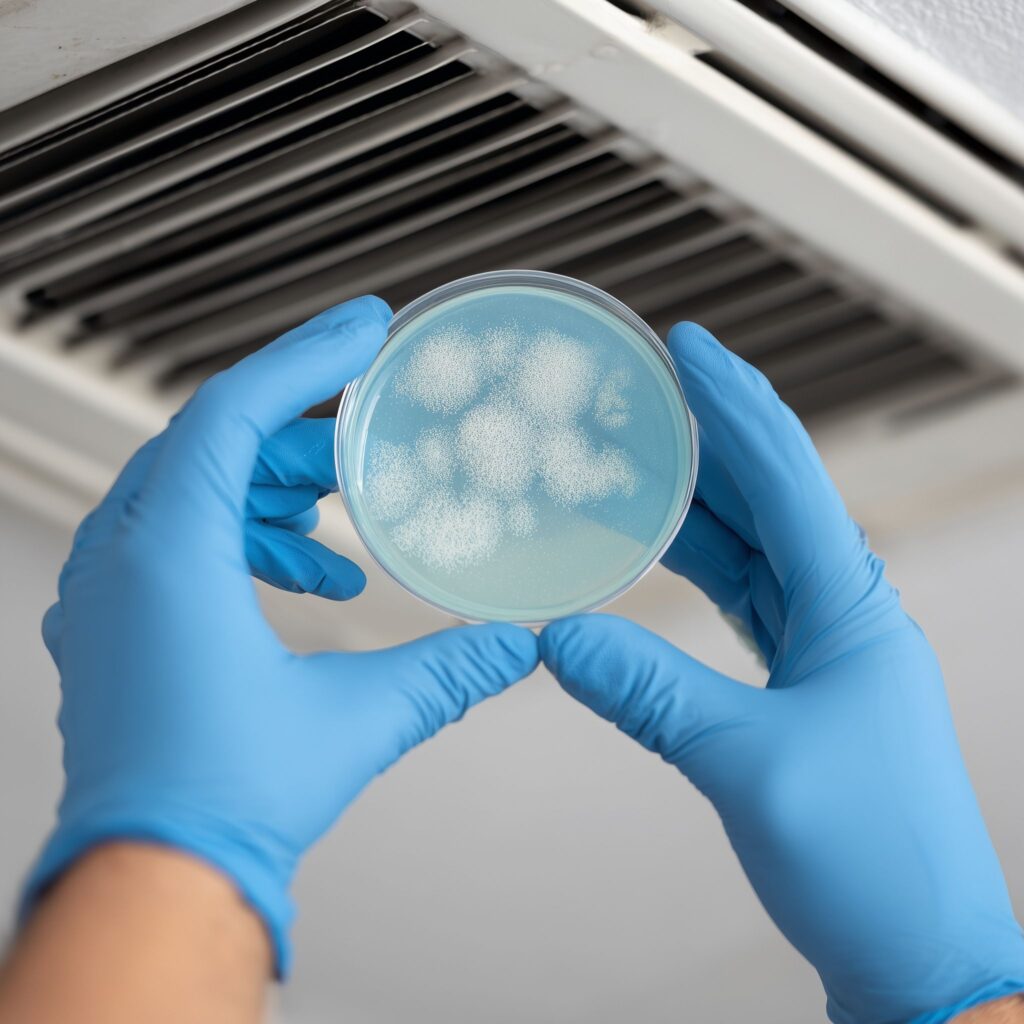

Indoor air quality plays a critical role in your family’s health and comfort. Yet, one of the most overlooked aspects of maintaining clean air is air duct cleaning. Air ducts serve as the lungs of your home, circulating air from your heating, ventilation, and air conditioning (HVAC) system throughout every room. Over time, these ducts can become contaminated with dust, mold, bacteria, soot, fibers, and other harmful particulates that compromise both system efficiency and indoor air quality.
In this guide, we’ll cover everything you need to know about air duct cleaning—its importance, recommended frequency, how humidifiers affect cleaning schedules, how to choose a qualified cleaning company, and why air duct cleaning is essential for preventing exposure to toxic mold, fine particulate matter (PM), silicates, soot, and fiberglass. We’ll also explore how IndoorDoctor On-Demand can help test for molds and allergens through our Mold and Allergen On-Demand Testing Package.
Why Air Duct Cleaning Matters
Air ducts are pathways for conditioned air, but they also collect dust, debris, and contaminants over time. Every time your system cycles, these pollutants can be released back into your living space. According to the U.S. Environmental Protection Agency (EPA), indoor air can be 2 to 5 times more polluted than outdoor air, largely due to trapped contaminants and poor ventilation .
Common pollutants that accumulate in air ducts include:
- Dust mites and dander (from people and pets)
- Mold spores and fungal growth
- Soot and combustion byproducts
- Fiberglass particles from deteriorating insulation
- Silica dust from construction or renovation work
- Pollen and allergens
Over time, this buildup can contribute to allergies, asthma, sinus problems, respiratory irritation, and even systemic health issues when toxic molds are involved.

How Often Should Air Ducts Be Cleaned?
While the National Air Duct Cleaners Association (NADCA) recommends cleaning every 3 to 5 years, your specific environment may require more frequent service .
You should consider cleaning your ducts more often if:
- You’ve recently renovated or remodeled your home.
- You have pets that shed hair or dander.
- You or a family member suffer from allergies or asthma.
- You use a humidifier, as higher moisture levels can promote mold growth inside ducts.
- There is visible mold growth or a musty odor coming from vents.
- You’ve experienced smoke damage or had a nearby wildfire.
- You live near busy roads or industrial areas where soot and particulate matter are higher.
The Role of Humidifiers
Humidifiers add moisture to indoor air, which can be beneficial during dry seasons. However, excess humidity can create a perfect environment for mold and bacterial growth inside air ducts and coils. Homeowners who use whole-home humidifiers should schedule annual duct inspections and cleanings to prevent microbial contamination .
The Dangers of Toxic Mold and Harmful Particulate Matter (PM)

Mold Contamination in Air Ducts
When mold spores find moisture inside ductwork, they can quickly colonize. Certain species—such as Stachybotrys, Aspergillus, and Alternaria—produce mycotoxins, which are known to cause respiratory distress, neurological symptoms, and fatigue . Because ducts circulate air throughout the home, mold spores can spread rapidly, contaminating other surfaces.
Harmful Particulates: PM, Silicates, Soot, and Fibers
Particulate matter (PM) refers to tiny airborne particles that can penetrate deep into the lungs. The World Health Organization (WHO) classifies PM2.5 (particles smaller than 2.5 micrometers) as a major contributor to cardiovascular and respiratory diseases .
Air ducts can harbor:
- Soot from fireplaces, candles, and fuel-burning appliances
- Silicates and silica dust from drywall, tile, or masonry
- Fiberglass fragments from damaged insulation or deteriorating duct liner
- Textile fibers and carpet debris
These particulates can irritate lung tissue, worsen asthma, and contribute to long-term inflammation.

How Air Duct Cleaning Is Performed
A professional air duct cleaning involves multiple steps designed to safely remove contaminants without redistributing them into your home’s air.
1. System Inspection
The technician begins by inspecting your HVAC system, including supply and return ducts, registers, coils, and blower motors. Video inspection tools or cameras may be used to detect mold growth, debris buildup, or damaged components.
2. Negative Pressure Vacuuming
The cleaning company will attach a high-powered vacuum to your duct system to create negative pressure. This prevents contaminants from escaping into your home during cleaning.
3. Agitation and Brushing
Specialized rotary brushes and air whips dislodge dust, mold, and debris from duct walls. Flexible agitation tools are often used to navigate bends and joints.
4. Source Removal and HEPA Filtration
The vacuum system pulls dislodged material into HEPA-filtered containment units, capturing fine particles and mold spores down to 0.3 microns.
5. Sanitization and Optional Coating
If microbial contamination is detected, EPA-approved disinfectants or antimicrobial treatments may be applied. In some cases, internal duct coatings are used to seal porous surfaces or damaged fiberglass liners.
What to Watch Out for: Flex Hose and Fiberglass Issues
Flex Hose Damage
Flexible ducting, often made of thin plastic with a wire coil, can easily tear, collapse, or detach over time. If a flex hose is broken or loose, it can cause air leaks, reduce HVAC efficiency, and draw in contaminants from attics or crawl spaces . During cleaning, technicians should inspect all connections and repair or replace compromised sections.
Loose or Exposed Fiberglass
Older duct systems may contain fiberglass liners that deteriorate and release fibers into the air. Inhalation of fiberglass particles can cause respiratory irritation and coughing. If you notice fibrous dust around vents, it may indicate that the insulation inside your ducts is breaking down .

Choosing a Qualified Air Duct Cleaning Company
Because air duct cleaning is not federally regulated, it’s important to select a reputable company that follows industry standards. Here’s what to look for:
- NADCA Certification
Choose a provider certified by the National Air Duct Cleaners Association (NADCA). This ensures adherence to the ACR Standard, which outlines proper cleaning methods, equipment use, and safety protocols. - Use of HEPA Filtration Equipment
Ensure the company uses negative air machines with HEPA filters to prevent dust and spores from escaping. - Transparent Pricing and Process
Avoid companies offering “whole-house specials” for unrealistically low prices. These are often scams or partial cleanings. - Before-and-After Documentation
Reputable companies provide photo or video evidence showing the condition of ducts before and after cleaning. - Mold-Qualified Professionals
If mold is suspected, confirm that the provider has experience in mold remediation and follows EPA and IICRC guidelines.
The Importance of Indoor Air Quality Testing
Even after air duct cleaning, contaminants can re-enter your environment through leaks, moisture intrusion, or hidden mold sources. This is why professional indoor air quality (IAQ) testing is essential for understanding the health of your indoor environment.
What IAQ Testing Can Reveal
- Levels of mold spores and allergens
- Concentrations of particulate matter (PM2.5 and PM10)
- Presence of volatile organic compounds (VOCs)
- Detection of asbestos, fiberglass, or silicates
IndoorDoctor’s On-Demand Mold and Allergen Testing
IndoorDoctor’s Mold and Allergen Virtual Testing Package allows homeowners to test their indoor air remotely using professional-grade equipment and laboratory analysis. The package includes:
- Step-by-step instructions with expert virtual guidance
- Collection media for molds and allergens
- Certified laboratory analysis
- Comprehensive report with expert interpretation
This service provides fast, reliable results—without requiring an in-person visit. It’s ideal for confirming whether your air duct cleaning has effectively reduced airborne contaminants or if further remediation is needed.
Signs You Need Air Duct Cleaning or Testing
You should consider professional inspection if you notice:
- Persistent dust buildup on surfaces despite regular cleaning
- Musty or earthy odors from HVAC vents
- Allergy symptoms that worsen indoors
- Dark residue around vent covers (possible soot or mold)
- Uneven airflow or higher-than-usual energy bills
Ignoring these signs allows contaminants to circulate unchecked, putting your health and comfort at risk.
Conclusion: Protect Your Health and Home with Regular Air Duct Maintenance
Clean air ducts are vital for a healthy home environment. Regular inspection, cleaning, and air quality testing protect your family from mold exposure, harmful particulates, and respiratory irritants. For homeowners with humidifiers, the need for frequent maintenance becomes even more important, as moisture accelerates microbial growth.
By partnering with qualified professionals and leveraging testing solutions like IndoorDoctor’s Mold and Allergen On-Demand Testing Package, you can confidently assess and improve your indoor air quality—ensuring a safer, cleaner, and more comfortable home.
References
- U.S. Environmental Protection Agency (EPA). “The Inside Story: A Guide to Indoor Air Quality.” https://www.epa.gov/indoor-air-quality-iaq
- National Air Duct Cleaners Association (NADCA). “How Often Should You Clean Your Air Ducts?” https://nadca.com/homeowners
- American Society of Heating, Refrigerating and Air-Conditioning Engineers (ASHRAE). “Humidity Control and Mold Prevention.”
- Centers for Disease Control and Prevention (CDC). “Mold: General Information and Health Effects.” https://www.cdc.gov/mold/
- World Health Organization (WHO). “Health Effects of Particulate Matter.” https://www.who.int
- U.S. Department of Energy (DOE). “Guide to Home Duct Systems.” https://www.energy.gov/
- Agency for Toxic Substances and Disease Registry (ATSDR). “Fiberglass and Health Effects.” https://www.atsdr.cdc.gov/
- IndoorDoctor. “Mold and Allergen Virtual Testing Package.”
